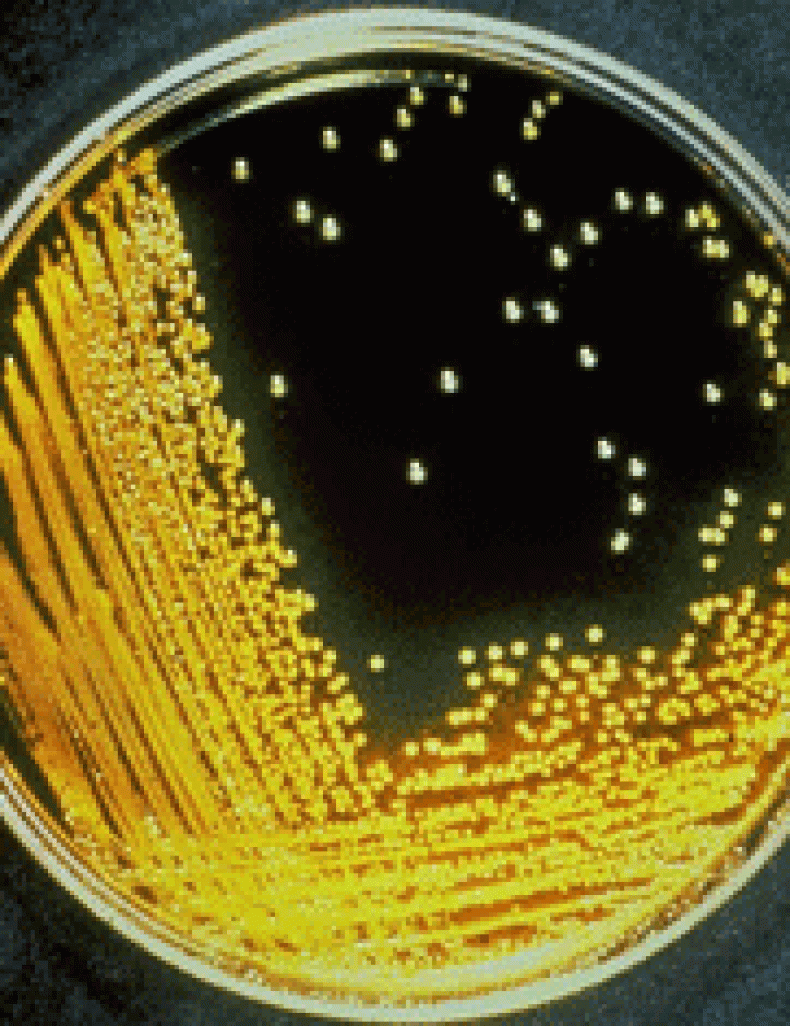

06/ 39030481 - messaggi WhatsApp al 346/ 6000899 - [email protected] Sede: Via Piave, 76 - Roma
- Encefalite da zecche: consigli per Scout e esploratori
- VIDEO Meningite: una guida per i giovani
- ENCEFALITE DA ZECCHE (ITALIA – EUROPA – ASIA) PROTEGGITI E VACCINATI SUBITO
- Meningite: il killer silenzioso che colpisce i giovani
- Soggetti over 65 e Viaggiatori: perché il vaccino Anti-Pneumococco è indispensabile